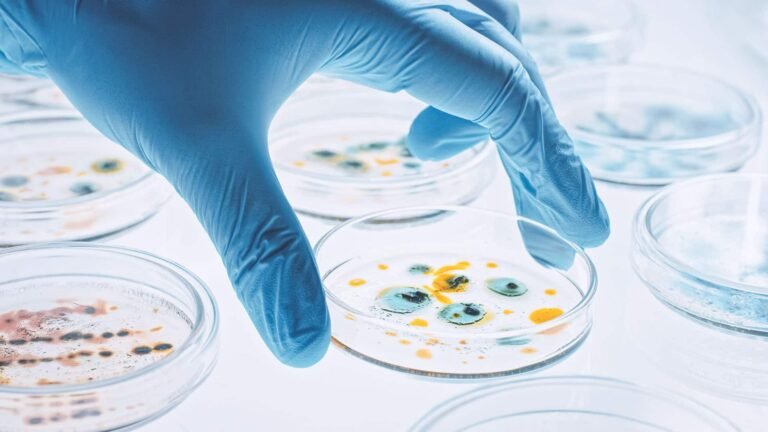
Foto: Laboratório

Criação e Curadoria
Larissa F. Araújo
Professora, PhD em Epidemiologia
Você é um profissional ou estudante da área da saúde, vai fazer prova de concurso, residência ou ingressar no mestrado / doutorado e precisa aprender tudo sobre Epidemiologia?
EpidemioPro é pra você.